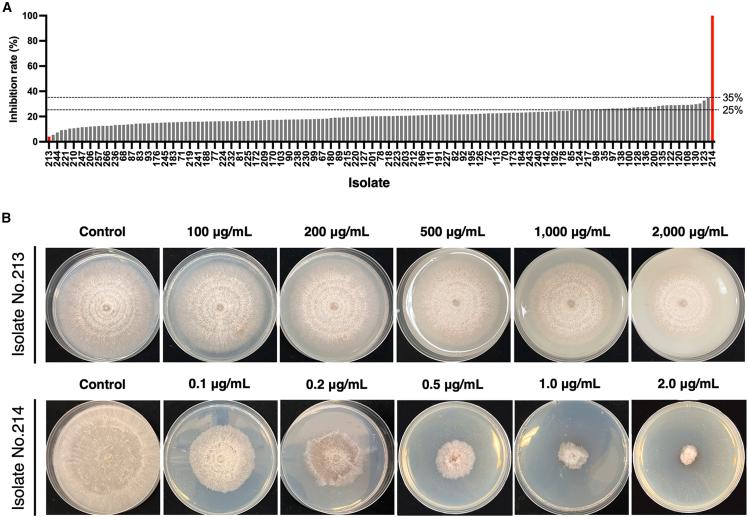
https://cdn.ncbi.nlm.nih.gov/pmc/blobs/47c7/12205815/d01fef909067/gr1.jpg

比较基因组学和转录组学鉴定出对戊菌隆抗性的AG-7细胞色素P450基因。
Comparative genomics and transcriptomics identify AG-7 cytochrome P450 gene for pencycuron resistance.
作者信息
Chen Yi-Jyun, Lee Miin-Huey, Sang Hyunkyu, Chang Hao-Xun
机构信息
Department of Plant Pathology and Microbiology, National Taiwan University, Taipei 106319, Taiwan.
Department of Plant Pathology, National Chung Hsing University, Taichung 40277, Taiwan.
出版信息
iScience. 2025 May 26;28(7):112756. doi: 10.1016/j.isci.2025.112756. eCollection 2025 Jul 18.
is a destructive fungal pathogen that causes major crop losses worldwide. The fungicide pencycuron is commonly used to control Rhizoctonia diseases, but some anastomosis groups (AGs) such as AG-7 are generally resistant to pencycuron. This study discovered a sensitive AG-7 isolate (No.214), and compared its genomics and transcriptomics to a resistant isolate (No.213). PacBio whole-genome sequencing and Illumina RNA sequencing (RNA-seq) revealed that No.214 has a whole-genome duplicated and pentaploid genome, showed broad transcriptional changes but lacked key detoxification genes in response to pencycuron. In contrast, No. 213 has a diploid genome and the transcriptional responses were mostly xenobiotic detoxification genes such as cytochrome P450 (). Functional validation in confirmed conferred pencycuron resistance. Collectively, this work advances the understanding of cytochrome P450-mediated pencycuron resistance and suggests genomic complexity of AG-7 isolates may influence pencycuron susceptibility.
是一种具有破坏性的真菌病原体,在全球范围内导致主要作物损失。杀菌剂戊菌隆通常用于防治丝核菌病,但一些融合群(AGs),如AG - 7,通常对戊菌隆具有抗性。本研究发现了一个敏感的AG - 7分离株(214号),并将其基因组学和转录组学与一个抗性分离株(213号)进行了比较。PacBio全基因组测序和Illumina RNA测序(RNA - seq)显示,214号具有全基因组复制和五倍体基因组,表现出广泛的转录变化,但缺乏响应戊菌隆的关键解毒基因。相比之下,213号具有二倍体基因组,转录反应主要是细胞色素P450等外源解毒基因。在 中的功能验证证实 赋予了戊菌隆抗性。总体而言,这项工作推进了对细胞色素P450介导的戊菌隆抗性的理解,并表明AG - 7分离株的基因组复杂性可能影响戊菌隆的敏感性。